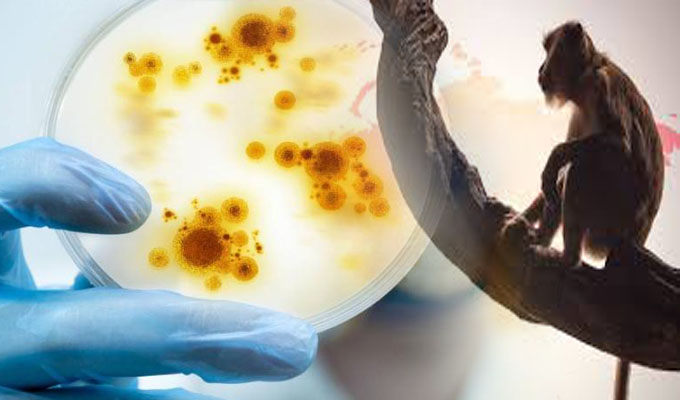

Esta mañana, la Organización Mundial de la Salud (OMS) anunció que se ha informado de casi 200 casos de la llamada “viruela del mono” en más de 20 países.
Pero para la OMS esta enfermedad como una epidemia es "contenible" y propuso crear una reserva para compartir equitativamente las limitadas vacunas y medicamentos disponibles en todo el planeta.
Como se recuerda hace unos días, Argentina confirmó el primer caso de “viruela del mono” en Latinoamérica e informó que hay otro sospechoso de padecerla.
Ayer, Ecuador confirmó su primer caso, tras activar un cerco epidemiológico sobre una persona procedente desde el continente de África y sus contactos cercanos ante la sospecha de que podría estar contagiada de viruela símica.
Cabe señalar que España, Inglaterra y Portugal son los países con más casos con esta enfermedad vírica.





